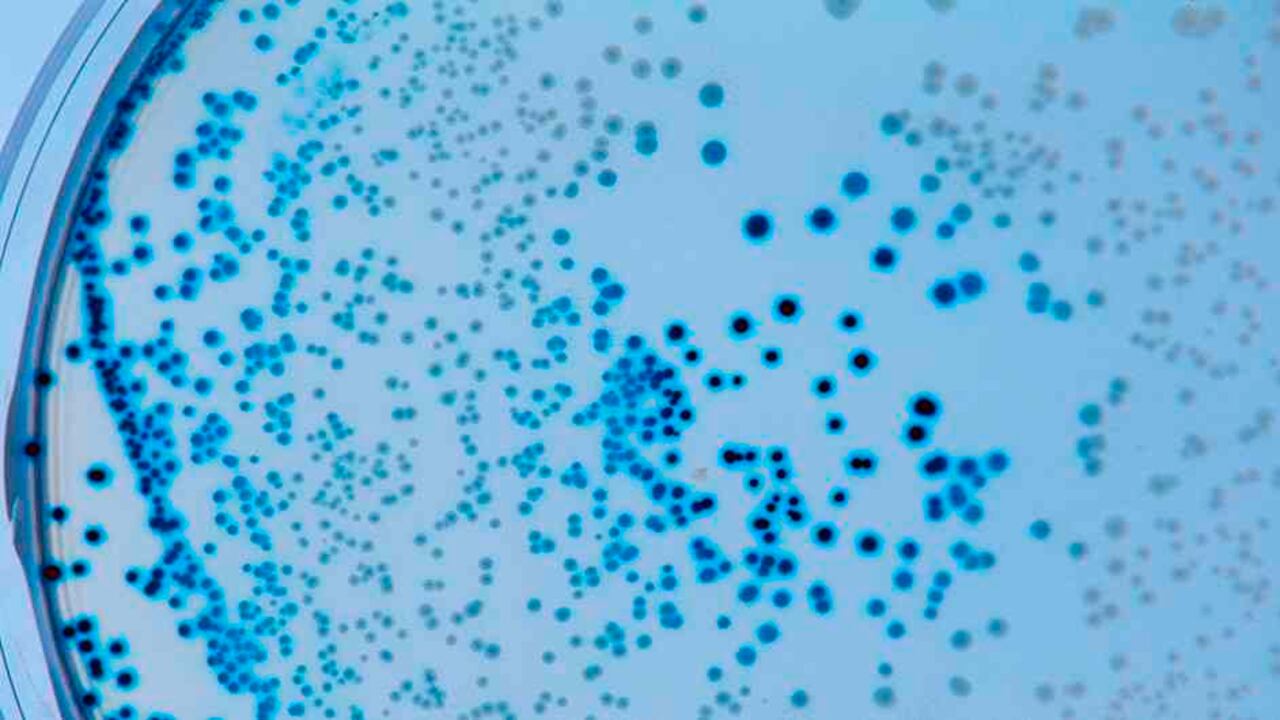
Las 9 preguntas para entender la nueva cepa del coronavirus que llega a Latam

El profesor Ravi Gupta, un microbiólogo de la Universidad de Cambridge, aseguró que los fabricantes de las vacunas contra el coronavirus deben desarrollar otras para combatir las mutaciones que se han registrado hasta el momento.
El científico asegura que las mutaciones reducirán la efectividad de las vacunas actuales y que es posible que en un tiempo dejen de funcionar las que actualmente existen.
“Las vacunas que tenemos ahora deberían funcionar contra el virus actual, pero deberían mantenerse actualizadas con nuevas variantes en caso de que mute tanto que dejen de funcionar”, dijo en un medio internacional.
Además, agregó que, si la eficacia de la vacuna es baja, existen altas probabilidades de que las personas se puedan contagiar pese a haber recibido la inmunización.

Según Gupta, las principales cepas de covid-19 se han presentado en Inglaterra, Sudáfrica y Brasil. Además, encontró que la que surgió en el primer país “podría reducir la eficacia de la vacuna de Pfizer”.
“Ha llegado el momento, necesitamos nuevas vacunas ahora. Sabemos qué mutaciones están apareciendo y nos llevará meses, hagamos lo que hagamos”, añadió.
Sin embargo, de acuerdo con los resultados de los últimos ensayos clínicos, la fórmula contra el coronavirus desarrollada por Pfizer y BioNTech sería efectiva contra la cepa detectada en el Reino Unido, que ya se ha extendido por varios países.
El último estudio llevado a cabo al respecto, el cual no ha sido revisado por homólogos, incluyó 10 mutaciones características de la variante conocida como B117, identificada en Reino Unido.
Por lo tanto, dichos resultados estuvieron basados en un análisis de sangre de los participantes en los ensayos. Se asegura que los estudios también fueron más extensos que los publicados por el fabricante de medicamentos estadounidense la semana pasada.

“Si las vacunas no se mantienen al día con los cambios, existe el riesgo de que las mutaciones menores se sumen y se acumulen como una bola de nieve para cambiar significativamente el virus y hacer que las vacunas sean menos efectivas”, señaló el profesor.
Asimismo, indicó que los brotes podrían aumentar después de que todas las personas hayan sido inoculadas.
No obstante, hasta el momento, la cepa más preocupante fue la que surgió en Sudáfrica, seguida de las dos variantes de Brasil, ya que según el científico si una persona ya estuvo contagiada de covid-19 puede contraer de nuevo el virus de las nuevas cepas.
“Adaptar las vacunas para hacer frente a las nuevas variantes del virus debería ser relativamente sencillo para los expertos que trabajan en ellas”, agregó Gupta.
De hecho, un portavoz de AstraZeneca afirmó: “La Universidad de Oxford y los laboratorios de todo el mundo están evaluando cuidadosamente el impacto de las nuevas variantes en la efectividad de la vacuna, y están iniciando los procesos necesarios para el desarrollo rápido de vacunas covid-19 ajustadas si es necesario”.

Según diferentes instituciones y expertos en temas de la salud, el coronavirus es cada vez más diverso debido al alto número de contagios, que ya supera los 96,2 millones. Ello le permite a este virus, en cada nuevo contagio, mutar mientras hace copias de sí mismo.
“El hecho de que hayamos observado tres variantes de preocupación desde septiembre sugiere que es probable que haya más en el futuro”, indicó en su cuenta de Twitter el biólogo Trevor Bedford, del Centro de Investigación del Cáncer Fred Hutchinson en Seattle.
La variante británica ha sido localizada ya en 50 países, y la sudafricana, en 20, según la Organización Mundial de la Salud (OMS), que señala que este censo está probablemente subestimado.
Otra variante, originaria de la Amazonía brasileña, cuyo hallazgo anunció el domingo Japón, está siendo analizada y podría impactar la respuesta inmunitaria, según la OMS, que habla de una “variante preocupante”.